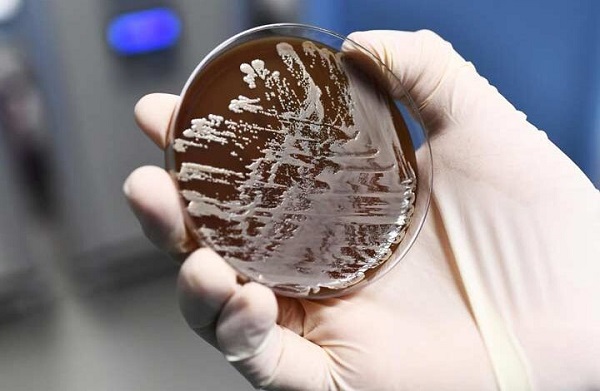

به گزارش بهداشت نیوز، همه پیامدهای تغییرات آب و هوایی خیلی قابل توجه نیستند. بر اساس یک مطالعه جدید توسط یک تیم بین المللی از محققان، یکی از اثرات کمتر شناخته شده و در عین حال قابل توجه گرم تر شدن دریاها، گسترش باکتری های گوشت خوار در آب های ساحلی است، جایی که می توانند انسان را حتی در هوای مناسب به طور خطرناکی بیمار کنند.
به طور خاص، این مطالعه به گونه ای بدنام به نام Vibrio vulnificus می پردازد که برای آلوده کردن انسان ها فعالیت می کند. وقتی کسی غذاهای دریایی خام یا نیم پز، به ویژه صدف می خورد، می تواند به آن مبتلا شود، اما در صورت قرار گرفتن در معرض زخم باز، می تواند فاشئیت نکروزان را تهدید کند.
محققان این مطالعه گزارش می دهند که V. vulnificus که مدتها پیش از آبهای ساحلی در خلیج مکزیک و سواحل اقیانوس اطلس در جورجیا و فلوریدا شناخته می شد، به نظر می رسد تهدیدی رو به رشد در این مناطق باشد و در عین حال زیستگاههای جدیدی را در شمال تهدید می کند.
در طی یک دوره ۳۰ ساله، تعداد عفونت های V. vulnificus در امتداد ساحل شرقی ایالات متحده از ۱۰ به ۸۰ در سال افزایش یافت. پژوهشگران اضافه می کنند که موارد ابتلا نیز هر سال دورتر از شمال ظاهر می شوند.
محققان پیشبینی می کنند:عفونت V. vulnificus می تواند طی چند دهه آینده نیویورک را درگیر کند. دانشمندان می گویند که مطالعه آنها اولین موردی است که چگونگی تغییر مکان های عفونت V. vulnificus در امتداد سواحل ایالات متحده را در طول زمان ترسیم می کند، و اولین مطالعه ای است که بررسی می کند چگونه تغییرات آب و هوایی ممکن است همچنان بر گسترش آن در آینده تأثیر بگذارد.
در حالی که تعداد کلی عفونت های ایالات متحده نسبتاً کم است، خطرات آن زیاد است: طبق گفته مرکز کنترل و پیشگیری از بیماری های ایالات متحده (CDC)، حدود یک نفر از هر پنج نفر با زخم آلوده به V. vulnificus می میرند. اطلاعات همچنین نشلن می دهند که بسیاری از بازماندگان هنوز به مراقبت های ویژه یا قطع اندام نیاز دارند.
این مطالعه به رهبری الیزابت آرچر (Elizabeth Archer) زمینشناس در دانشگاه آنگلیا شرقی در بریتانیا، آنچه را که بهعنوان یک تهدید رو به رشد اما نادیده گرفته شده برای سلامت عمومی ناشی از تغییرات آب و هوایی توصیف می شود، برجسته می کند.
آرچر می گوید: انتشار گازهای گلخانه ای ناشی از فعالیتهای انسانی آب و هوای ما را تغییر داده و تأثیرات آن ممکن است به ویژه در خطوط ساحلی جهان که مرز اصلی بین اکوسیستمهای طبیعی و جمعیتهای انسانی را ایجاد می کنند و منبع مهم بیماریهای انسانی هستند، شدید باشد.
او می افزاید: پژوهش های ما نشان داد که تا پایان قرن بیست و یکم، عفونتهای V. vulnificus بیشتر به سمت شمال گسترش خواهند یافت، اما میزان آن به درجه گرمایش و به انتشار گازهای گلخانه ای آینده بستگی دارد.
افزایش دما در حال حاضر به گسترش بسیاری از عوامل بیماریزا از جمله بیماریهای منتقله از پشه و برخی قارچهای بیماریزا کمک کرده و به نظر می رسد این همان موضوعی است که با V. vulnificus و گرم شدن آبهای ساحلی اتفاق می افتد.
شرح کامل این مطالعه در Scientific Reports منتشر شده است.
منبع: سیناپرس